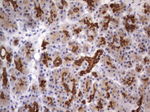
Acidic Cytokeratin Antibody in Immunohistochemistry (Paraffin) (IHC (P))

Search
OriGene
Acidic Cytokeratin Monoclonal Antibody (OTI8F5), TrueMAB™
{{$productOrderCtrl.translations['antibody.pdp.commerceCard.promotion.promotions']}}
{{$productOrderCtrl.translations['antibody.pdp.commerceCard.promotion.viewpromo']}}
{{$productOrderCtrl.translations['antibody.pdp.commerceCard.promotion.promocode']}}: {{promo.promoCode}} {{promo.promoTitle}} {{promo.promoDescription}}. {{$productOrderCtrl.translations['antibody.pdp.commerceCard.promotion.learnmore']}}
产品信息
TA190168
种属反应
宿主/亚型
分类
类型
克隆号
抗原
偶联物
形式
浓度
纯化类型
保存液
内含物
保存条件
运输条件
产品详细信息
Synthetic peptide sequence is EKVTMQNLND RLASYLDKVR ALEEAN
靶标信息
Cytokeratin pan is part of a subfamily of intermediate filament proteins that are characterized by remarkable biochemical diversity, and represented in human epithelial tissues by at least 20 different polypeptides. Cytokeratins range in molecular weight between 40 kDa- 68 kDa, and an isoelectric pH between 4.9-7.8. The individual human cytokeratins are numbered 1 to 20. The various epithelia in the human body usually express cytokeratins which are not only characteristic of the type of epithelium, but also related to the degree of maturation or differentiation within an epithelium. Cytokeratin subtype expression patterns are used to an increasing extent in the distinction of different types of epithelial malignancies. The cytokeratin antibodies are not only of assistance in the differential diagnosis of tumors using immunohistochemistry on tissue sections, but are also a useful tool in cytopathology and flow cytometric assays. The composition of cytokeratin pairs vary with the epithelial cell type, stage of differentiation, cellular growth environment, and disease state. Many studies have shown the usefulness of keratins as markers in cancer research and tumor diagnosis.
仅用于科研。不用于诊断过程。未经明确授权不得转售。
篇参考文献 (0)
生物信息学
蛋白别名: 40-kDa keratin intermediate filament; Acidic Cytokeratin; Cell proliferation-inducing gene 46 protein; CK-10; CK-14; CK-15; CK-16; CK-18; CK-19; CK-9; cytokeratin 10; cytokeratin 14; cytokeratin 15; cytokeratin 16; cytokeratin 18; cytokeratin 19; cytokeratin 9; Cytokeratin-10; Cytokeratin-14; Cytokeratin-15; Cytokeratin-16; Cytokeratin-18; Cytokeratin-19; Cytokeratin-9; focal non-epidermolytic palmoplantar keratoderma; HMWCK; K10; K14; K15; K16; K18; K19; K9; keratin 10, type I; keratin 14, type I; keratin 15, type I; keratin 16, type I; keratin 18, type I; keratin 19, type I; keratin 9, type I; Keratin, type I cytoskeletal 10; Keratin, type I cytoskeletal 14; Keratin, type I cytoskeletal 15; Keratin, type I cytoskeletal 16; Keratin, type I cytoskeletal 18; Keratin, type I cytoskeletal 19; Keratin, type I cytoskeletal 9; keratin, type I, 40-kd; Keratin-10; Keratin-14; Keratin-15; keratin-15, basic; keratin-15, beta; Keratin-16; Keratin-18; Keratin-19; Keratin-9; pan keratin; pankeratin; type I cytoskeletal 15; type I cytoskeletal 9
基因别名: BCIE; BIE; CK-18; CK-9; CK10; CK14; CK15; CK16; CK19; CYK18; EBS3; EBS4; EHK; EPPK; FNEPPK; K10; K14; K15; K16; K18; K19; K1CO; K1CP; K1CS; K9; KPP; KRT10; KRT14; KRT15; KRT16; KRT16A; KRT18; KRT19; KRT9; KRTB; NEPPK; NFJ; PC1; PIG46
UniProt ID: (Human) P13645, (Human) P02533, (Human) P19012, (Human) P08779, (Human) P05783, (Human) P08727, (Human) P35527
Entrez Gene ID: (Human) 3858, (Human) 3861, (Human) 3866, (Human) 3868, (Human) 3875, (Human) 3880, (Human) 3857